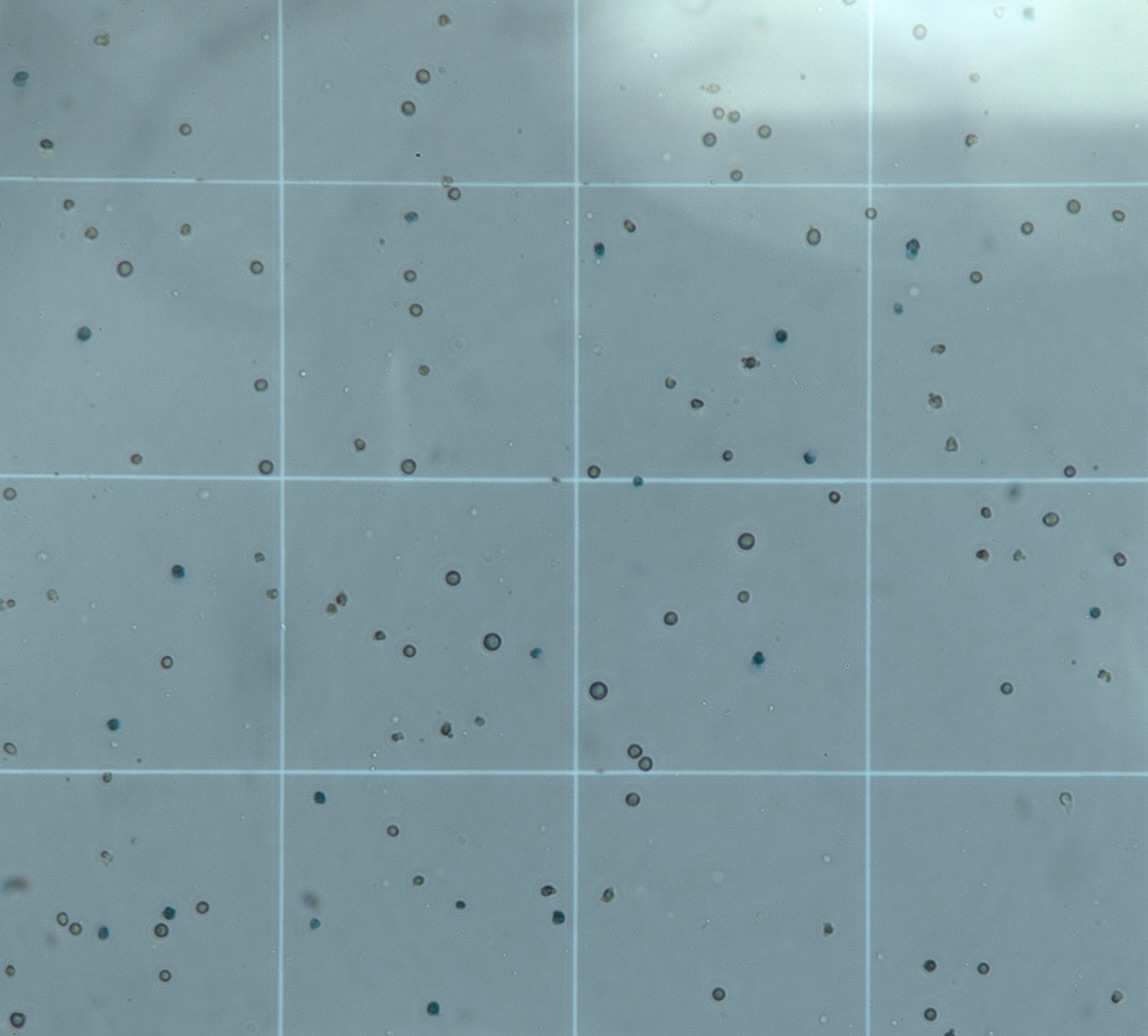

The RapidSelection™ test overcomes previous biological and clinical barriers to personalized cancer therapy. Past efforts have focused on measuring cell death, a process that can take over a week and has shown no sustainable clinical success. Since a cell’s weight change ex vivo happens in hours, we eliminate the difficulty of having to distinguish between natural cell death and cell death induced by a cancer drug.
Preliminary studies have shown that RapidSelection™ test applies to many different cancer drugs with different mechanisms of action across 90% of cancers.